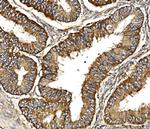
C19orf52 Antibody in Immunohistochemistry (Paraffin) (IHC (P))

Search
Invitrogen
C19orf52 Polyclonal Antibody
{{$productOrderCtrl.translations['antibody.pdp.commerceCard.promotion.promotions']}}
{{$productOrderCtrl.translations['antibody.pdp.commerceCard.promotion.viewpromo']}}
{{$productOrderCtrl.translations['antibody.pdp.commerceCard.promotion.promocode']}}: {{promo.promoCode}} {{promo.promoTitle}} {{promo.promoDescription}}. {{$productOrderCtrl.translations['antibody.pdp.commerceCard.promotion.learnmore']}}
图: 1 / 6
C19orf52 Antibody (PA5-144070) in ICC/IF

Please note: We are reviewing Western blot images included in the antibody testing data in our catalog, including those provided by third parties. Unless expressly labeled or annotated as “raw-unedited”, Western blot images included in the antibody testing data in our catalog may have been edited, optimized or otherwise adjusted for presentation.
产品信息
PA5-144070
种属反应
宿主/亚型
分类
类型
抗原
偶联物
形式
浓度
规格
纯化类型
保存液
内含物
保存条件
运输条件
RRID
产品详细信息
Adding 0.2 mL of distilled water will yield a concentration of 500 µg/mL.
Positive Control - WB: human PC-3 whole cell, human HEK293 whole cell, human K562 whole cell. IHC: human breast cancer tissue, human lymphoma tissue, human endometrial cancer tissue. ICC/IF: PC-3 cell. Flow: MCF-7 cell.|Store at -20°C for one year from date of receipt. After reconstitution, at 4°C for one month. It can also be aliquotted and stored frozen at -20°C for six months. Avoid repeated freeze-thaw cycles.
靶标信息
TIMM29, also known as C19orf52, is identified as a novel subunit of the human TIM22 complex, which plays a critical role in the mitochondrial inner membrane. This protein is crucial for the stability of the TIM22 complex, which is responsible for the translocation of hydrophobic inner mitochondrial membrane proteins carrying internal targeting signals. TIMM29/C19orf52 is integrated into the mitochondrial inner membrane, exposing its C-terminus to the intermembrane space, and is vital for mitochondrial function and protein import pathways. This gene's importance is underscored by its involvement in processes related to mitochondrial integrity and its potential role in neurodegenerative disorders and viral interactions, such as those with the hepatitis B virus (HBV).
仅用于科研。不用于诊断过程。未经明确授权不得转售。
篇参考文献 (0)
生物信息学
蛋白别名: Mitochondrial import inner membrane translocase subunit Tim29; TIM29
基因别名: c19orf52; TIMM29
Entrez Gene ID: (Human) 90580




